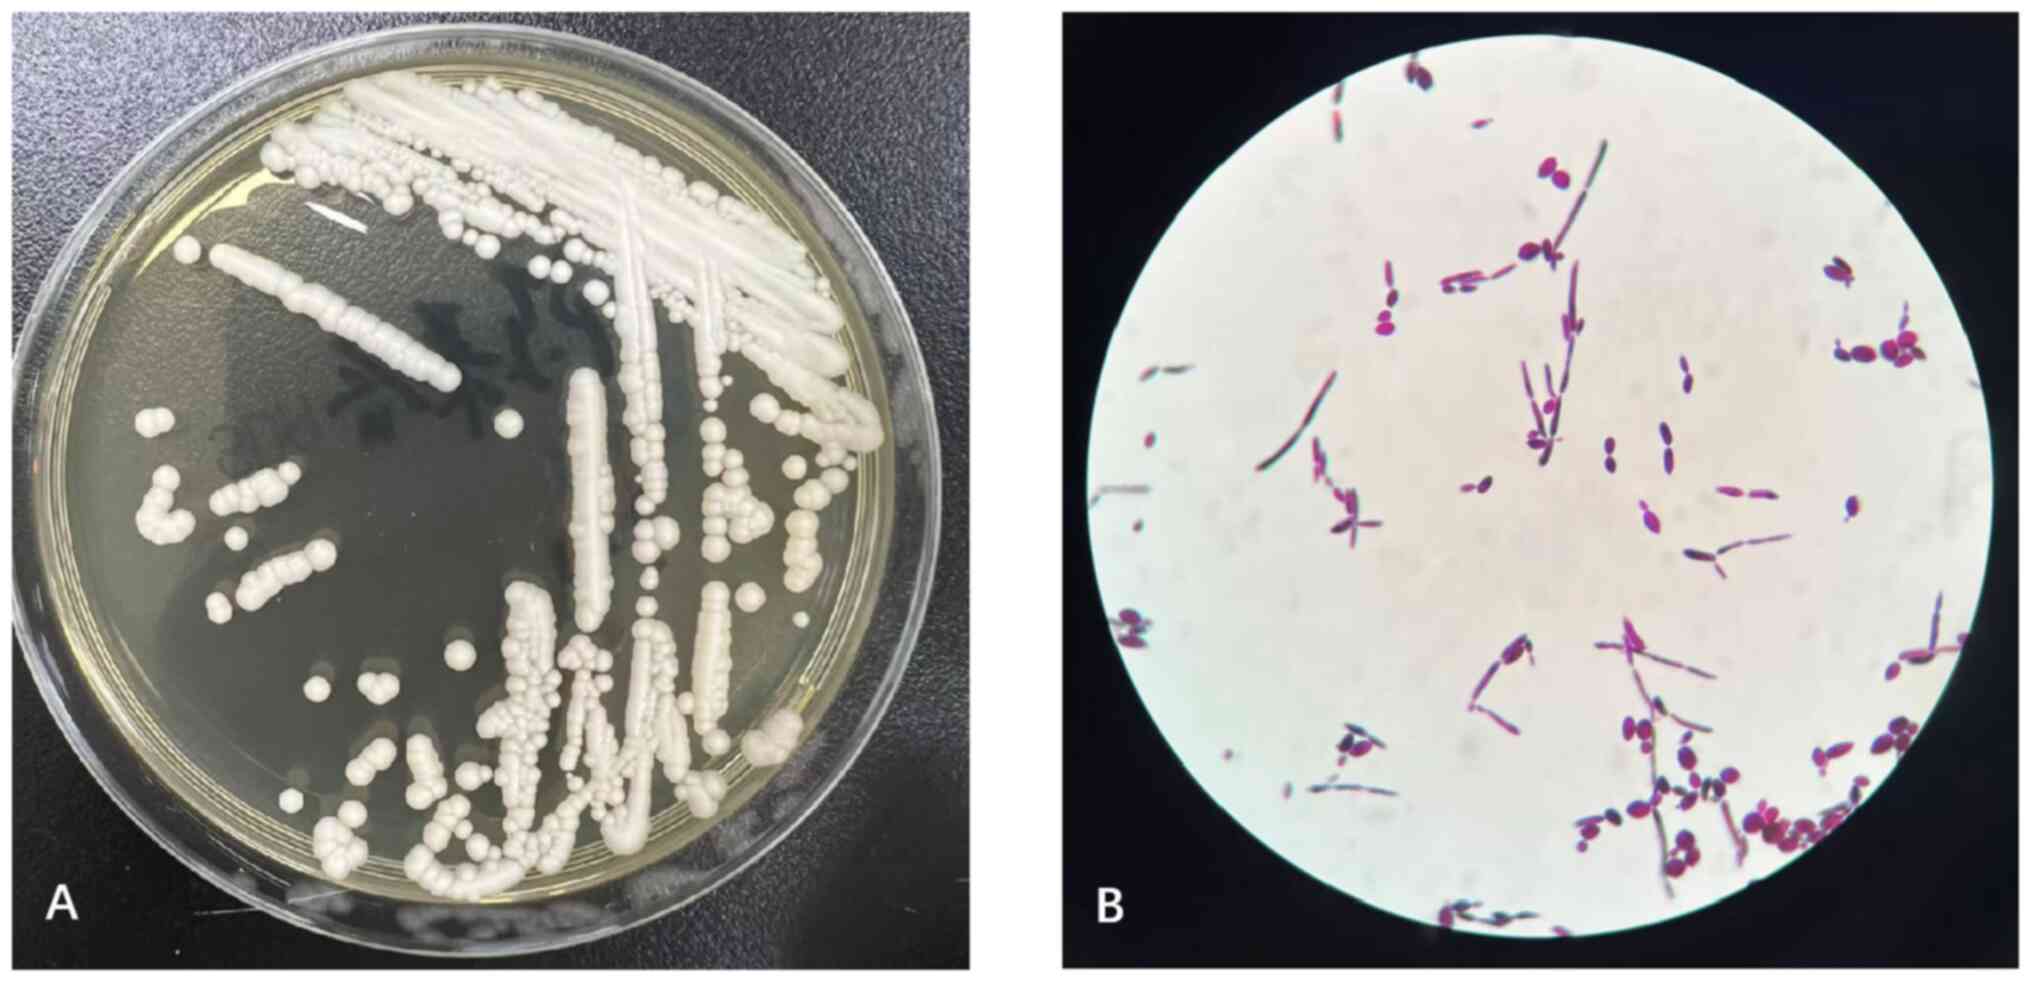

|
1
|
Fernández-Ruiz M, Guinea J, Puig-Asensio
M, Zaragoza Ó, Almirante B, Cuenca-Estrella M and Aguado JM:
CANDIPOP Project; GEIH-GEMICOMED (SEIMC) and REIPI. Fungemia due to
rare opportunistic yeasts: data from a population-based
surveillance in Spain. Med Mycol. 55:125–136. 2017.PubMed/NCBI View Article : Google Scholar
|
|
2
|
Jayaweera JAAS, Kothalawala M and Sooriyar
S: Infected tricuspid valve myxoma with Kodamaea ohmeri:
Case report. Indian J Med Microbiol. 39:252–255. 2021.PubMed/NCBI View Article : Google Scholar
|
|
3
|
Hou C: Catheter-related bloodstream
infection caused by Kodamaea ohmeri in China. Infect Prev
Pract. 1(100006)2019.PubMed/NCBI View Article : Google Scholar
|
|
4
|
Santino I, Bono S, Borruso L, Bove M,
Cialdi E, Martinelli D and Alari A: Kodamaea ohmeri isolate
from two immunocompromised patients: First report in Italy.
Mycoses. 56:179–181. 2013.PubMed/NCBI View Article : Google Scholar
|
|
5
|
Guo DW, Gao J, Wu HL, Wu C, Wu JX, Rui Q,
Bao Y, Liu ZH, Wang XY, Xu LD, et al: Extracorporeal membrane
oxygenation combined with minimally invasive surgery for acute
respiratory failure and sudden cardiac arrest: A case report. Exp
Ther Med. 25(250)2023.PubMed/NCBI View Article : Google Scholar
|
|
6
|
Tsao NW, Shih CM, Yeh JS, Kao YT, Hsieh
MH, Ou KL, Chen JW, Shyu KG, Weng ZC, Chang NC, et al:
Extracorporeal membrane oxygenation-assisted primary percutaneous
coronary intervention may improve survival of patients with acute
myocardial infarction complicated by profound cardiogenic shock. J
Crit Care. 27:530.e1–e11. 2012.PubMed/NCBI View Article : Google Scholar
|
|
7
|
Frerou A, Lesouhaitier M, Gregoire M, Uhel
F, Gacouin A, Reizine F, Moreau C, Loirat A, Maamar A, Nesseler N,
et al: Venoarterial extracorporeal membrane oxygenation induces
early immune alterations. Crit Care. 25(9)2021.PubMed/NCBI View Article : Google Scholar
|
|
8
|
Cho HJ, Kayumov M, Kim D, Lee K, Onyekachi
FO, Jeung KW, Kim Y, Suen JY, Fraser JF and Jeong IS: Acute immune
response in venoarterial and venovenous extracorporeal membrane
oxygenation models of rats. ASAIO J. 67:546–553. 2021.PubMed/NCBI View Article : Google Scholar
|
|
9
|
Ki KK, Millar JE, Langguth D, Passmore MR,
McDonald CI, Shekar K, Shankar-Hari M, Cho HJ, Suen JY and Fraser
JF: Current understanding of leukocyte phenotypic and functional
modulation during extracorporeal membrane oxygenation: A narrative
review. Front Immunol. 11(600684)2021.PubMed/NCBI View Article : Google Scholar
|
|
10
|
Calderón Checa RM, Rojo Conejo P,
González-Posada Flores AF, Llorente de la Fuente AM, Palacios
Cuesta A, Aguilar JM and Belda Hofheinz S: Experience with
infections in the use of extracorporeal membrane oxygenation. An
Pediatr (Engl Ed). 89:86–91. 2018.PubMed/NCBI View Article : Google Scholar : (In Spanish).
|
|
11
|
MacLaren G, Schlapbach LJ and Aiken AM:
Nosocomial infections during extracorporeal membrane oxygenation in
neonatal, pediatric, and adult patients: A comprehensive narrative
review. Pediatr Crit Care Med. 21:283–290. 2020.PubMed/NCBI View Article : Google Scholar
|
|
12
|
Biffi S, Di Bella S, Scaravilli V, Peri
AM, Grasselli G, Alagna L, Pesenti A and Gori A: Infections during
extracorporeal membrane oxygenation: Epidemiology, risk factors,
pathogenesis and prevention. Int J Antimicrob Agents. 50:9–16.
2017.PubMed/NCBI View Article : Google Scholar
|
|
13
|
Allou N, Lo Pinto H, Persichini R, Bouchet
B, Braunberger E, Lugagne N, Belmonte O, Martinet O, Delmas B,
Dangers L and Allyn J: Cannula-related infection in patients
supported by peripheral ECMO: Clinical and microbiological
characteristics. ASAIO J. 65:180–186. 2019.PubMed/NCBI View Article : Google Scholar
|
|
14
|
Kim HS, Park S, Ko HH, Ha SO, Lee SH and
Kim YK: Different characteristics of bloodstream infection during
venoarterial and venovenous extracorporeal membrane oxygenation in
adult patients. Sci Rep. 11(9498)2021.PubMed/NCBI View Article : Google Scholar
|
|
15
|
Kanno Y, Wakabayashi Y, Ikeda M, Tatsuno
K, Misawa Y, Sato T, Yanagimoto S, Okugawa S, Moriya K and
Yotsuyanagi H: Catheter-related bloodstream infection caused by
Kodamaea ohmeri: A case report and literature review. J
Infect Chemother. 23:410–414. 2017.PubMed/NCBI View Article : Google Scholar
|
|
16
|
Yu Q, Yan J, Gao Z, Yang H, Tang Y and
Yang L: Subcutaneous granuloma caused by Kodamaea ohmeri in
an immunocompromised patient in China. Australas J Dermatol.
61:e213–e216. 2020.PubMed/NCBI View Article : Google Scholar
|
|
17
|
Ma XF, Hu WB, Wang GQ, Gao WM, Wang MS,
Tong GA, Zhu L and Zhu Y: A case of patient with Pichia
ohmeri fungemia associated with HLD successfully treated with
caspofungin and a literature review. Anhui Med J. 37:136–139.
2016.(In Chinese).
|
|
18
|
Tashiro A, Nei T, Sugimoto R, Watanabe A,
Hagiwara J, Takiguchi T, Yokota H and Kamei K: Kodamaea
ohmeri fungemia in severe burn: Case study and literature
review. Med Mycol Case Rep. 22:21–23. 2018.PubMed/NCBI View Article : Google Scholar
|
|
19
|
Wang CH, Su YS and Lee WS: Necrotizing
cellulitis caused by Kodamaea ohmeri fungemia in a
HIV-infected patient. J Infect. 84:579–613. 2022.PubMed/NCBI View Article : Google Scholar
|
|
20
|
Zhou M, Li Y, Kudinha T, Xu Y and Liu Z:
Kodamaea ohmeri as an emerging human pathogen: A review and
update. Front Microbiol. 12(736582)2021.PubMed/NCBI View Article : Google Scholar
|
|
21
|
Diallo K, Lefevre B, Cadelis G, Gallois
JC, Gandon F, Nicolas M and Hoen B: A case report of fungemia due
to Kodamaea ohmeri. BMC Infect Dis. 19(570)2019.PubMed/NCBI View Article : Google Scholar
|
|
22
|
Ascioglu S, Rex JH, de Pauw B, Bennett JE,
Bille J, Crokaert F, Denning DW, Donnelly JP, Edwards JE, Erjavec
Z, et al: Defining opportunistic invasive fungal infections in
immunocompromised patients with cancer and hematopoietic stem cell
transplants: An international consensus. Clin Infect Dis. 34:7–14.
2002.PubMed/NCBI View
Article : Google Scholar
|
|
23
|
Zhou M, Yu S, Kudinha T, Xiao M, Wang H,
Xu Y and Zhao H: Identification and antifungal susceptibility
profiles of Kodamaea ohmeri based on a seven-year
multicenter surveillance study. Infect Drug Resist. 12:1657–1664.
2019.PubMed/NCBI View Article : Google Scholar
|
|
24
|
Ioannou P and Papakitsou I: Kodamaea
ohmeri infections in humans: A systematic review. Mycoses.
63:636–643. 2020.PubMed/NCBI View Article : Google Scholar
|
|
25
|
Mei Y, Chen X, Sun K, Lv J, Sun H and
Zhang J: Scedosporium apiospermum infection: Lethal
complication after extracorporeal cardiopulmonary resuscitation.
Perfusion. 33:71–73. 2018.PubMed/NCBI View Article : Google Scholar
|